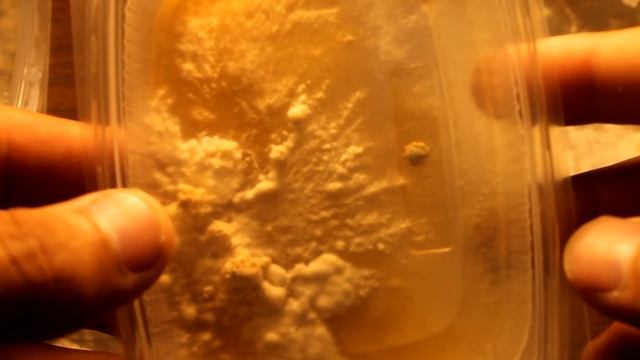
ежевик VS плесень смотреть онлайн

Автор / Канал: Вкусовые Эмоции Страница 3

Лавна, без преувеличения #кебаб #Lavna

ПРОРАЩИВАНИЕ СЕМЯН В УЛИТКЕ vselennaya uvlesheniy

how to make popcorn without microwave(как приготовить попкорн без микроволновки )

Шиповник

Prepare a Cappuccino Ice with your NESCAFÉ® Dolce Gusto® Oblo coffee machine by Krups®

Как Сделать Хороший ДИЗАЙН - ПРОЕКТ? Нужен Ли ОН? Этапы Проектирования

ВПР/КДР ПО МАТЕМАТИКЕ // РАЗБИРАЕМ ЗАДАНИЯ ◆ 29

#ԾԱՂԿԱԿԱՂԱՄԲ ԿԱՄ #ԲՐՈԿՈԼԻՆ ՀԱՎԻ ԴՈՇՈՎ ԱՆԱՀԻՏԻՑ #цветная #капуста с грудкой в соевом соусе

Как все быстро! Кролики размножаются, цесарки вылупляются!

Английские прилагательные на A Часть 1
ежевик VS плесень

Белая Армия Чёрный Барон... песня про Красную Армию

Обед без хлопот.Рыба с рисом в мультиварке PHILIPS HD4726/

СКУМБРИЯ БАЛЫҒЫН ДУХОВКАДА/ПЕШТЕ ПІСІРУ. Казакша рецепт. Балык пісіру. Онай рецепт. Дәмді балық

Варим вкусное яблочное пюре

DIY: образ комнаты в летнем стиле//готовим комнату к лету.

Черное тайское мороженое на "Белагро-2022"

Готовим пиццу !#вкусно#весело#класснооооооо???

Готовьтесь крякскому апрелю=)

VLOG: ROOM TOUR # Не хочу готовить, болтушка?

Готовим шашлык с Коляном!

Как правильно готовить KFC в домашних условиях!!! ??? 100% рецепт кфс

ОГЭ Английский язык Speaking Task 2 (telephone survey) Films

Хинкальная в печатниках
За каждым успешным каналом стоит личность, идея и сотни часов кропотливого труда. Если вы здесь, значит, автор «Вкусовые Эмоции» уже сумел зацепить ваше внимание своим уникальным стилем или подачей. А мы на RUVIDEO позаботились о том, чтобы вы могли изучить весь архив его работ в максимально комфортных условиях — без лишней суеты и преград.
Почему за работами канала «Вкусовые Эмоции» так интересно наблюдать? Всё просто: это честный контент, который находит отклик в сердцах зрителей. На нашем ресурсе вы можете смотреть онлайн все видео любимого автора бесплатно и в хорошем качестве. Нам важно, чтобы вы видели каждую деталь и слышали каждый нюанс, поэтому мы используем только стабильные плееры из открытых источников Rutube.
Следите за новинками канала, пересматривайте старые шедевры и открывайте для себя новые грани творчества «Вкусовые Эмоции». Мы постоянно обновляем ленту, чтобы у вас под рукой всегда были самые свежие выпуски. Никаких сложных регистраций — только вы и творчество, которое вдохновляет. Приятного вам путешествия по миру авторского контента на RUVIDEO!
Видео взято из открытых источников Rutube. Если вы правообладатель, обратитесь к первоисточнику.